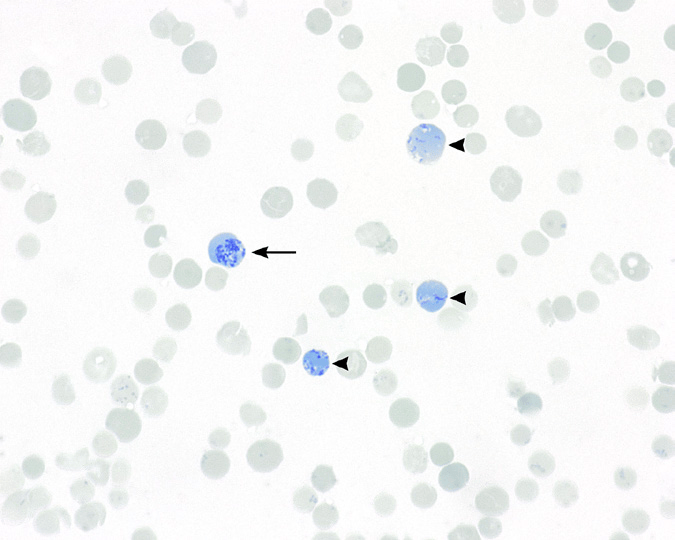
红细胞形态评估:总结正常红细胞,多染性细胞和网织红细胞

正常红细胞图

(图) 正常红细胞
图片尺寸1140x818
正常红细胞
图片尺寸1200x919
正常红细胞
图片尺寸1200x827
世界首例人造红细胞用于人体试验改善稀有血型患者治疗
图片尺寸720x723
正常红细胞
图片尺寸640x400
正常红细胞医学背景照片
图片尺寸450x300
正常红细胞(图片来源网络)
图片尺寸600x600
血涂片中正常血红细胞.
图片尺寸1200x901
新鲜红细胞
图片尺寸1100x1108
3.血小板:个体最小,形态不规则,无细胞核,有止血和加速凝血的作用.
图片尺寸1080x385
检验|正常红系,粒系,淋巴细胞形态
图片尺寸1920x2560
红细胞形态评估:总结正常红细胞,多染性细胞和网织红细胞
图片尺寸675x540
(图:shutterstock)▼显微镜下的红细胞凝集,透着点诡异1900年,奥地利
图片尺寸3024x3024
地贫|红细胞|血常规|血小板|癌症患者_网易订阅
图片尺寸660x615
正常红细胞图片素材下载 - veer图库
图片尺寸800x533
「转发」正常骨髓细胞形态图集(1)
图片尺寸897x900
hemoglobin toxicity
图片尺寸1500x1125
原始红细胞血细胞形态学检查
图片尺寸872x1163
x医生谈血液 | 红细胞真的是细胞吗?
图片尺寸965x705
正常红细胞背景实验室概念.
图片尺寸800x746